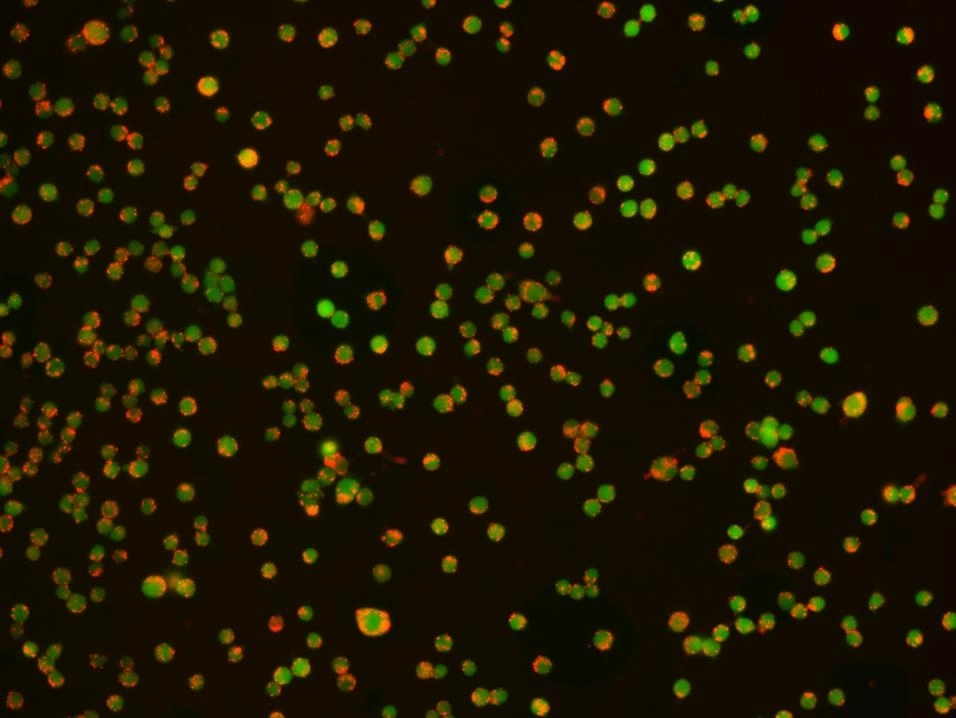
Phagocytosis examined by Protonex™ Red 600-Latex Bead Conjugate (Cat # 21209)

Nanoparticles
Nanoparticles and particle-based supports are essential tools for immunopurification, protein isolation, flow cytometry calibration, and cellular uptake studies. AAT Bioquest offers a range of fluorescent latex bead conjugates, agarose resins, and magnetic beads optimized for research applications.
For bioconjugation reagents compatible with particle surfaces, see our Bioconjugation and Tags catalog.
Protonex™ latex bead conjugates exhibit unique pH-dependent fluorescence—unlike most fluorescent dyes, acidic conditions enhance their fluorescence (pKa ~6.5). This property makes them ideal for phagocytosis assays, where engulfed particles enter acidic phagolysosomal compartments. The lack of fluorescence outside cells eliminates wash steps, and red-shifted conjugates enable multiplexing with GFP, Fluo-8®, calcein, or FITC-labeled antibodies.
Fig. 1
Phagocytosis was examined in RAW 264.7 cells by Protonex™ Red 600-Latex Bead Conjugate (Catalog Number 21209). The cells were incubated with Protonex™ 600 Latex Beads in growth medium for 4 hours. CytoTrace™ Green CMFDA (Catalog Number 22017) was used to track live cells. The image (20X) was taken using Keyence Fluorescence Microscopy.
Beadlite™ kits enable rapid colorimetric quantitation of functional groups on nanoparticle and bead surfaces, a critical step for quality control during bioconjugation.
This kit (Catalog Number 5532) measures amine density using absorbance readings at 650 nm with Bucculite™ MTA-Dye.
The standard kit (Catalog Number 5533) uses DTNB/Ellman's method, with absorbance readings at 412 nm, to quantify surface maleimides. The 680 nm-optimized kit (Catalog Number 5534) uses Maleimide 680™ (ε = 250,000 M⁻¹cm⁻¹) for enhanced sensitivity.
This kit (Catalog Number 5535) uses Thiolite™ 490 for sulfhydryl detection, reading absorbances at 490 nm. It is compatible with cuvettes, NanoDrop™, or plate readers.
This document (01.0205.251203r1) was last updated on Sat Feb 28 2026. All trademarks and registered trademarks mentioned herein are the property of their respective owners.
